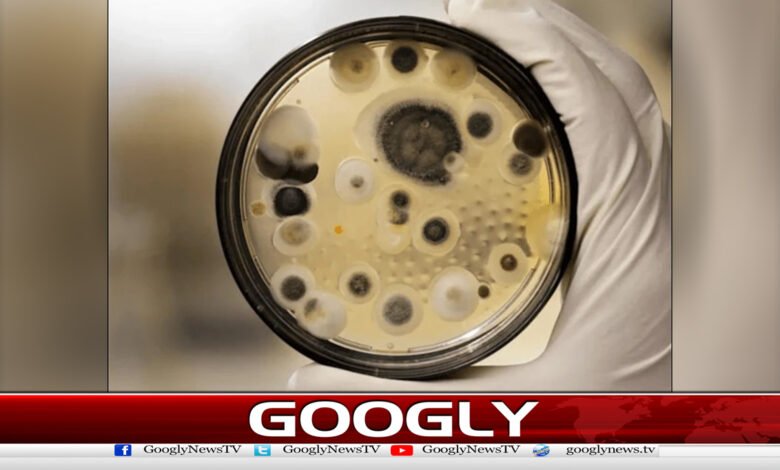
Fear of deadly fungus spreading among humans

انسانوں میں قاتل فنگس پھیلنےکاخدشہ
قاتل فنگس جو اندر سے انسان کو کھا جاتا ہے،سائنسدانوں نےنئی عالمی وباکے خطرہ سے آگاہ کردیا۔
سوچیے، اگر آپ روزانہ ایک ایسی چیز کو سانس کے ذریعے اپنے جسم میں داخل کر رہے ہوں، جو کسی دن آپ کو اندر سے کھا جائے؟ یہ کوئی فلمی کہانی نہیں بلکہ ایک تلخ سچ ہے جسے سائنسدانوں نے حالیہ تحقیق میں بے نقاب کیا ہے۔ایک مہلک فنگس، جس کا نام ایسپرجیلوس ہے، اب پہلے سے کہیں زیادہ خطرناک اور تیزی سے پھیلتا ہوا دکھائی دے رہا ہے، اور اس کا نشانہ صرف انسان ہی نہیں، جانور اور پودے بھی ہیں۔
یہ فنگس انسانوں میں ایسپرجیلوسس نامی بیماری کا باعث بنتا ہے، جو پھیپھڑوں پر حملہ کرتی ہے اور جان لیوا ثابت ہو سکتی ہے۔ برطانیہ کی مانچسٹر یونیورسٹی کے سائنسدانوں نے خبردار کیا ہے کہ موسمیاتی تبدیلیوں کے باعث دنیا کے درجہ حرارت میں جو اضافہ ہو رہا ہے، وہ اس مہلک فنگس کےلیے نئے دروازے کھول رہا ہے۔ اب یہ مائیکروبس ان علاقوں کی طرف بڑھ رہا ہے جہاں اس کا وجود پہلے ممکن نہیں تھا، جیسے شمالی امریکا، یورپ، چین اور روس۔
تحقیق کے مطابق، ایسپرجیلوس کی بعض اقسام ’’ماحولیاتی سپروٹروف‘‘ کہلاتی ہیں، جو نہ صرف انسانی جسم بلکہ جانوروں اور پودوں میں بھی خطرناک انفیکشنز پیدا کرسکتی ہیں۔
